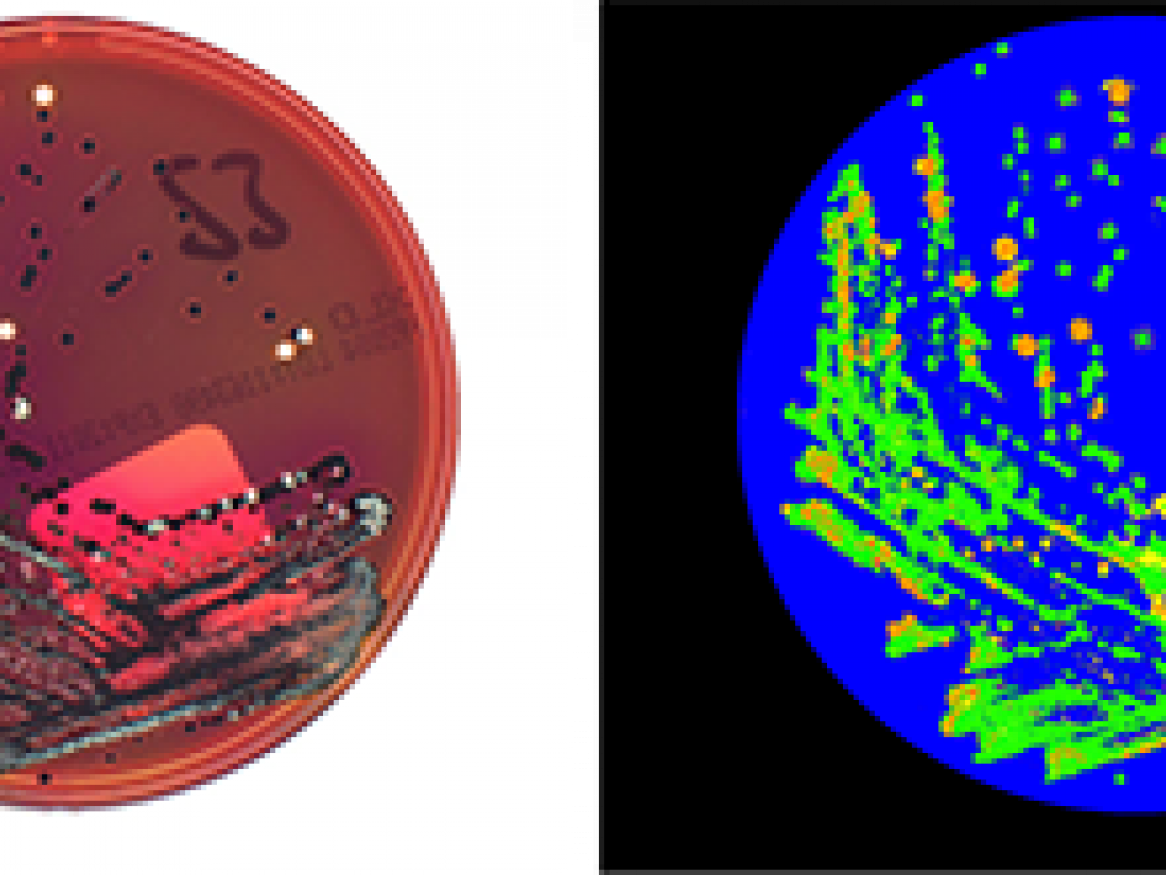
Biomed

News: Award
AIML PhD student awarded 2021 Google PhD Fellowship

AIML PhD student Xinlong Wang has been awarded the 2021 Google PhD Fellowship in Machine Perception, Speech Technology and Computer Vision.
[Read more about AIML PhD student awarded 2021 Google PhD Fellowship]
Professor Ian Reid named a Fellow of Australian Academy of Science

Congratulations to Professor Ian Reid for his appointment as a Fellow of the Australian Academy of Science!
[Read more about Professor Ian Reid named a Fellow of Australian Academy of Science]
AIML Co-Director Professor Anton van den Hengel awarded prestigious fellowship

Congratulations to AIML’s Co-Director Professor Anton van den Hengel who was named as a 2020 Fellow of the Academy of Technology and Engineering.
[Read more about AIML Co-Director Professor Anton van den Hengel awarded prestigious fellowship]
Professor Carneiro and Dr Maicas finalists in Minister's Research and Innovation Award
Congratulations to Professor Gustavo Carneiro and Dr Gabriel Maicas on being selected as finalists for the Minister's Research and Innovation Award.
Dr Qi Wu wins prestigious J G Russell Award
The Australian Academy of Science has announced the successful recipients of this year’s J G Russell Award, which includes AIML’s Dr Qi Wu.
[Read more about Dr Qi Wu wins prestigious J G Russell Award]
First place!
Results for the REFUGE Retinal Fundus Glaucoma Challenge are in! First place in the Segmentation leaderboard and also in the Segmentation of Nuclei competition.
NVIDIA Pioneer Award

Dr Qi Wu (ACRV / AIML) has been awarded the prestigious NVIDIA Pioneer Award for his paper 'Learning semantic concepts and order for image and sentence matching' at the Computer Vision and Pattern Recognition conference in Salt Lake City.
We're number one in VQA 2.0

A team led by Damien Teney (AIML) and Peter Anderson (ACRV, ANU, and Microsoft) has just placed first in the VQA 2.0 challenge.
Award for Excellence in Collaboration
The collaboration between AIML and LBT Innovations won the SA Science Excellence award for Research Collaboration for the development of that APAS technology.
We're in the top 5 groups the world
The IEEE Conference on Computer Vision and Pattern Recognition (CVPR) is double blind reviewed (on full papers), and has the best citation rate in the field of computer vision and pattern recognition, according to the h5-index, a citation measure for the recent five years.